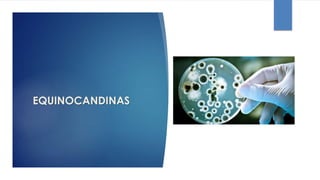
EQUINOCANDINAS

Este documento proporciona información sobre antimicóticos o antifúngicos. Explica que son sustancias que evitan el crecimiento o causan la muerte de hongos. Describe diferentes tipos de infecciones fúngicas y clasifica varios antimicóticos, incluyendo anfotericina B, nistatina, griseofulvina, miconazol e itraconazol. Para cada uno, brinda detalles sobre su mecanismo de acción, indicaciones, posología y otros aspectos farmacológicos.